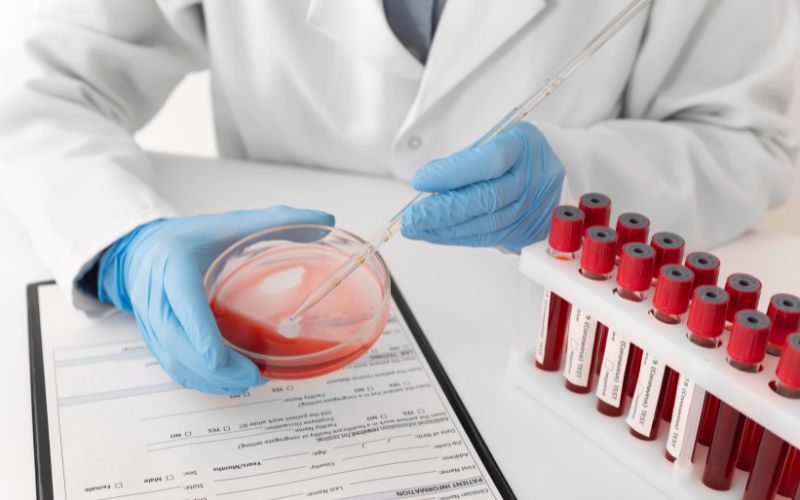
Máu trong cơ thể chúng ta chứa nhiều chất độc được tích tụ từ rất lâu trong cơ thể

Lọc máu xấu trẻ hoá làn da tái tạo năng lượng, làn da sáng khoẻ
Trong nhịp sống hiện đại đầy hối hả, việc chăm sóc sức khỏe từ sâu bên trong đang dần trở thành xu hướng. Các yếu tố như ô nhiễm môi trường, chế độ ăn uống không lành mạnh và căng thẳng kéo dài khiến cơ thể chúng ta tích tụ nhiều độc tố, ảnh hưởng trực tiếp đến làn da và sức khỏe tổng thể. Bài viết dưới đây sẽ khám phá chi tiết về phương pháp lọc máu xấu trẻ hoá làn da và những lợi ích vượt trội mà nó mang lại cho sức khỏe của bạn.
Tình trạng của làn da khi máu trong cơ thể nhiễm độc tố
Khi máu trong cơ thể bị nhiễm độc tố, làn da chính là "tấm gương" phản ánh rõ nhất tình trạng sức khỏe bên trong. Độc tố tích tụ lâu ngày không chỉ làm suy yếu các cơ quan nội tạng mà còn gây ra hàng loạt vấn đề về da, khiến làn da trở nên thiếu sức sống và lão hóa nhanh chóng.
Dưới đây là những dấu hiệu phổ biến khi máu bị nhiễm độc tố, khiến làn da trở nên xỉn màu, thô ráp, và kém săn chắc.
- Khi máu không được lọc sạch, độc tố tích tụ trong cơ thể khiến làn da trở nên xỉn màu và mất đi độ sáng tự nhiên. Da có thể trông mệt mỏi và không còn sự tươi tắn.
- Độc tố tích tụ trong máu khiến hệ bài tiết hoạt động kém hiệu quả, làm gia tăng mụn trứng cá, mụn đầu đen hoặc các tình trạng viêm da như mẩn ngứa, chàm.
- Máu bị nhiễm độc tố làm giảm khả năng giữ nước và dưỡng chất của da, khiến da trở nên khô, mất đàn hồi và dễ bị bong tróc.
- Khi cơ thể không thể loại bỏ độc tố, sự hình thành melanin trong da tăng lên, dẫn đến sự xuất hiện của nám, tàn nhang và các đốm nâu không đều màu.
- Lượng oxy và dưỡng chất giảm sút do máu bị nhiễm độc khiến quá trình tái tạo tế bào da bị suy yếu, làm da mất đi độ săn chắc và xuất hiện các dấu hiệu lão hóa sớm như nếp nhăn, chảy xệ.
- Khi độc tố không được đào thải, da sẽ phải hoạt động mạnh hơn để bài tiết qua tuyến mồ hôi và dầu nhờn, gây ra tình trạng lỗ chân lông to, dễ tích tụ bụi bẩn và vi khuẩn.

Từ đây cho chúng ta thấy, việc lọc máu xấu trẻ hoá làn da không chỉ có tác dụng làm sạch cơ thể mà còn là chìa khóa để trẻ hóa làn da, khôi phục vẻ tươi sáng tự nhiên.
Nguyên nhân tích tụ độc tố trong máu gây hại cho da
Khi máu trong cơ thể nhiễm độc tố, làn da thường là nơi biểu hiện rõ rệt nhất các dấu hiệu cảnh báo. Việc hiểu rõ những nguyên nhân gây tích tụ độc tố trong máu sẽ giúp chúng ta có cái nhìn toàn diện hơn về việc chăm sóc da, từ đó đưa ra các giải pháp hiệu quả để lọc máu xấu trẻ hoá làn da, thanh lọc cơ thể và phục hồi làn da từ bên trong.
Nguyên nhân tích tụ độc tố trong máu gây hại cho da:
- Thực phẩm chế biến sẵn và giàu đường, chất béo bão hòa là nguồn chính gây tích tụ độc tố trong máu, dẫn đến mụn và viêm da.
- Khói bụi và hóa chất từ môi trường xâm nhập vào cơ thể, tích tụ độc tố trong máu và làm da xỉn màu.
- Căng thẳng làm tăng cortisol và giảm khả năng thải độc, dẫn đến các vấn đề về da như khô ráp và mụn.
- Tiếp xúc lâu dài với hóa chất trong thuốc hoặc mỹ phẩm làm tăng độc tố trong máu, gây lão hóa da.
- Sử dụng rượu bia và thuốc lá làm suy giảm chức năng lọc máu của gan và thận, khiến da xuất hiện lỗ chân lông to và nếp nhăn sớm.

Tích tụ độc tố trong máu không chỉ làm suy yếu hệ miễn dịch mà còn ảnh hưởng nghiêm trọng đến làn da. Việc tìm hiểu và ngăn ngừa các nguyên nhân gây tích tụ độc tố sẽ giúp cải thiện sức khỏe tổng thể và mang lại làn da sáng mịn, khỏe mạnh từ bên trong.
Công nghệ lọc máu xấu trẻ hoá làn da hiện đại từ Nhật Bản
Lọc máu tuần hoàn Nhật Bản là một phương pháp lọc máu xấu trẻ hoá làn da với công nghệ y tế tiên tiến, giúp loại bỏ các yếu tố gây hại như cholesterol xấu, triglyceride, chất gây viêm, và virus khỏi máu bằng cách sử dụng một màng lọc đặc biệt. Quá trình này không chỉ làm sạch máu mà còn giúp cải thiện sức khỏe toàn diện, mang lại những lợi ích thiết thực cho cơ thể và làn da.
Khi máu được lọc sạch khỏi các độc tố và chất gây hại, cơ thể có khả năng hoạt động hiệu quả hơn. Công nghệ lọc máu hiện đại từ Nhật Bản không chỉ tập trung vào việc làm sạch máu mà còn hỗ trợ quá trình trẻ hóa làn da và tái tạo năng lượng. Khi độc tố và tạp chất được loại bỏ, làn da sẽ dần trở nên sáng mịn, đều màu và tràn đầy sức sống.
Phương pháp lọc máu xấu trẻ hoá làn da này còn giúp tăng cường sức đề kháng, cải thiện khả năng chống lại các bệnh tật và giảm cảm giác mệt mỏi. Bằng cách cải thiện chất lượng máu, lọc máu xấu trẻ hoá làn da từ Nhật Bản hỗ trợ việc cung cấp oxy và dưỡng chất cần thiết cho tế bào da, làm giảm sự hình thành nếp nhăn, tình trạng da khô ráp và mất đàn hồi.
Nhờ vào những tiến bộ trong công nghệ, lọc máu xấu trẻ hoá làn da hiện đại từ Nhật Bản không chỉ là một giải pháp hiệu quả để làm sạch cơ thể mà còn là phương pháp tối ưu để trẻ hóa làn da từ bên trong. Mang lại cho bạn sự trẻ trung, tươi mới và sức sống tràn đầy, giúp bạn cảm nhận sự khác biệt rõ rệt trong cả sức khỏe và vẻ đẹp tự nhiên của làn da.
Hiệu quả tuyệt vời lọc máu xấu trẻ hoá làn da
Lọc máu xấu trẻ hoá làn da là một phương pháp hiện đại và hiệu quả, không chỉ giúp làm sạch cơ thể mà còn mang lại những lợi ích đáng kể cho làn da. Dưới đây là những hiệu quả nổi bật của việc lọc máu xấu trẻ hoá làn da trong việc trẻ hóa và làm đẹp da:
Làm chậm quá trình lão hóa tự nhiên, giúp da tươi trẻ, rạng rỡ
Quá trình lọc máu xấu trẻ hoá làn da giúp loại bỏ các chất độc hại và tạp chất trong cơ thể, điều này làm giảm sự tích tụ của các yếu tố lão hóa. Khi máu sạch, các dấu hiệu lão hóa như nếp nhăn, da chảy xệ và mất đàn hồi được làm chậm lại. Da bạn sẽ duy trì được sự tươi trẻ và rạng rỡ lâu hơn, giúp bạn cảm nhận sự trẻ trung từ bên trong.

Máu sạch giúp cung cấp oxy và dưỡng chất tốt hơn cho da
Khi máu được lọc sạch khỏi các tạp chất và độc tố, khả năng cung cấp oxy và dưỡng chất cho da được cải thiện rõ rệt. Máu sạch giúp các tế bào da nhận đủ các yếu tố cần thiết để duy trì sức khỏe và sự tươi trẻ. Từ đó, lọc máu xấu trẻ hoá làn da làm cho làn da trở nên sáng và khỏe mạnh hơn, với màu sắc đều và tự nhiên. Đặc biệt, các dưỡng chất thiết yếu như vitamin và khoáng chất sẽ được vận chuyển hiệu quả hơn, giúp da nhận được sự chăm sóc tốt nhất từ bên trong.
Thúc đẩy quá trình tái tạo collagen tự nhiên, tăng độ đàn hồi cho da
Collagen là một thành phần quan trọng giúp da duy trì độ đàn hồi và sự săn chắc. Lọc máu xấu trẻ hoá làn da kích thích cơ thể sản xuất collagen mới, từ đó thúc đẩy quá trình tái tạo da. Collagen giúp làm đầy các nếp nhăn và vết chân chim, mang lại cho bạn làn da mịn màng và căng tràn sức sống. Nhờ vào việc cải thiện cấu trúc da, bạn sẽ thấy làn da trở nên săn chắc và trẻ trung hơn.

Loại bỏ các tác nhân gây mụn từ bên trong, làm sạch da từ gốc rễ
Máu bị nhiễm độc tố có thể là nguyên nhân gây ra các vấn đề về mụn, như mụn trứng cá, mụn đầu đen, và các tình trạng viêm da khác. Lọc máu xấu trẻ hoá làn da giúp loại bỏ những chất độc hại này khỏi cơ thể, từ đó giảm nguy cơ mắc các vấn đề về mụn. Quá trình lọc máu xấu trẻ hoá làn da làm sạch máu giúp cải thiện tình trạng da từ gốc rễ, làm giảm viêm và ngăn ngừa sự hình thành mụn, mang lại cho bạn làn da sạch sẽ và khỏe mạnh.
Máu sạch giúp cân bằng độ ẩm tự nhiên, làm da sáng mịn
Lọc máu xấu trẻ hoá làn da giúp cải thiện khả năng giữ ẩm của da bằng cách loại bỏ các tạp chất có thể làm giảm khả năng hấp thụ nước và dưỡng chất của da. Khi máu được làm sạch, da sẽ có khả năng duy trì độ ẩm tự nhiên tốt hơn, làm giảm tình trạng khô ráp và bong tróc. Kết quả là bạn sẽ có làn da mềm mại, sáng mịn và tràn đầy sức sống.
Nhờ vào những hiệu quả toàn diện mà lọc máu xấu trẻ hoá làn da mang lại, bạn có thể cảm nhận sự khác biệt rõ rệt trong sức khỏe và sắc đẹp của làn da. Phương pháp này giúp duy trì vẻ đẹp tự nhiên và sự trẻ trung từ bên trong, giúp bạn tự tin hơn với làn da tươi mới và khỏe mạnh.

Lọc máu xấu trẻ hoá làn da có an toàn hay không?
Lọc máu xấu trẻ hoá làn da là phương pháp hiện đại nhằm loại bỏ độc tố và tạp chất khỏi máu, giúp trẻ hóa làn da và cải thiện sức khỏe toàn diện. Được thực hiện bằng công nghệ tiên tiến và thiết bị hiện đại, liệu pháp này đảm bảo an toàn khi được thực hiện dưới sự giám sát của các bác sĩ và kỹ thuật viên có kinh nghiệm.
Quá trình lọc máu xấu trẻ hoá làn da thường không gây ra tác dụng phụ nghiêm trọng, mặc dù một số bệnh nhân có thể cảm thấy mệt mỏi nhẹ sau lọc máu. Phương pháp này không chỉ phù hợp với những người có vấn đề về sức khỏe mà còn với những ai muốn duy trì sắc đẹp và sức khỏe lâu dài.
Chỉ định và chống chỉ định lọc máu xấu trẻ hoá làn da
Lọc máu xấu trẻ hoá làn da là phương pháp tiên tiến giúp làm sạch máu. Để đạt được hiệu quả tối ưu và đảm bảo an toàn, quan tâm đến chỉ định và chống chỉ định lọc máu xấu trẻ hoá làn da là rất quan trọng.

Các đối tượng phù hợp lọc máu xấu trẻ hoá làn da:
- Những người gặp các vấn đề về da như mụn, nám, hoặc dấu hiệu lão hóa sớm có thể nhận được lợi ích to lớn từ việc lọc máu xấu trẻ hoá làn da. Phương pháp này giúp loại bỏ độc tố tích tụ trong cơ thể, làm sạch da từ bên trong, thúc đẩy tái tạo tế bào và mang lại làn da tươi sáng, rạng rỡ.
- Những người cảm thấy mệt mỏi và thiếu năng lượng có thể tìm thấy sự cải thiện đáng kể từ lọc máu xấu. Không chỉ lọc máu xấu trẻ hoá làn da mà còn giúp cải thiện lưu thông máu và cung cấp năng lượng cho cơ thể, giúp tăng cường sức sống và sự tỉnh táo.
- Những người thường xuyên tiếp xúc với ô nhiễm môi trường và hóa chất độc hại có nguy cơ cao tích tụ độc tố trong cơ thể. Phương pháp lọc máu xấu trẻ hoá làn da đồng thời hỗ trợ loại bỏ các tạp chất này, giúp bảo vệ sức khỏe tổng thể và cải thiện tình trạng da.
- Những người mong muốn nâng cao sức khỏe toàn diện, cải thiện sự trao đổi chất và tăng cường khả năng tự bảo vệ của cơ thể có thể tìm thấy “chìa khoá vàng” cho sức khỏe từ liệu pháp lọc máu xấu trẻ hoá làn da.
Đối tượng cần thận trọng, chú ý trước khi lọc máu xấu trẻ hoá làn da
- Những người mắc bệnh tim mạch nghiêm trọng hoặc có vấn đề về thận cần thận trọng khi thực hiện liệu pháp lọc máu xấu trẻ hoá làn da. Việc tham khảo ý kiến bác sĩ trước khi tiến hành liệu pháp là cần thiết để đảm bảo an toàn và phù hợp với tình trạng sức khỏe hiện tại.
- Phụ nữ đang mang thai hoặc cho con bú nên tham khảo ý kiến bác sĩ trước khi thực hiện lọc máu xấu trẻ hoá làn da. Đảm bảo rằng liệu pháp không gây ảnh hưởng tiêu cực đến sức khỏe của mẹ và bé, đồng thời đảm bảo sự an toàn trong quá trình điều trị.
- Những người có tiền sử dị ứng nghiêm trọng hoặc bệnh mãn tính cần thận trọng và tham khảo ý kiến bác sĩ trước khi thực hiện liệu pháp lọc máu xấu trẻ hoá làn da. Nhằm đảm bảo rằng liệu pháp không gây ra phản ứng phụ không mong muốn hoặc làm trầm trọng thêm tình trạng sức khỏe hiện tại.

Lưu ý quan trọng sau khi thực hiện lọc máu xấu trẻ hoá làn da
Sau khi thực hiện liệu pháp lọc máu xấu, việc chăm sóc bản thân đúng cách là rất quan trọng để duy trì hiệu quả điều trị và đảm bảo sức khỏe toàn diện. Dưới đây là những lưu ý quan trọng bạn cần lưu ý để đạt được kết quả tốt nhất:
Hạn chế đồ ăn nhiều đường, chất béo để duy trì hiệu quả lọc máu
Sau khi lọc máu xấu trẻ hoá làn da, việc duy trì chế độ ăn uống lành mạnh là rất quan trọng. Hạn chế tiêu thụ thực phẩm nhiều đường và chất béo để tránh làm tăng lượng độc tố trong cơ thể. Thay vào đó, hãy tập trung vào những thực phẩm giàu chất xơ và dinh dưỡng để hỗ trợ quá trình thanh lọc cơ thể và duy trì hiệu quả lâu dài của liệu pháp.

Tăng cường uống nước, bổ sung thực phẩm giàu vitamin và khoáng chất
Uống đủ nước là điều cần thiết để giúp cơ thể loại bỏ độc tố và duy trì làn da khỏe mạnh. Đồng thời, bổ sung thực phẩm giàu vitamin và khoáng chất sẽ cung cấp các dưỡng chất cần thiết cho cơ thể, hỗ trợ quá trình tái tạo da và làm tăng hiệu quả của liệu pháp lọc máu xấu trẻ hoá làn da.

Theo dõi phản ứng của cơ thể và làm theo hướng dẫn của chuyên gia
Sau liệu pháp lọc máu xấu trẻ hoá làn da, bạn cần chú ý theo dõi bất kỳ phản ứng nào từ cơ thể và làm theo hướng dẫn của chuyên gia, bác sĩ chuyên khoa. Giúp đảm bảo rằng cơ thể đang phục hồi tốt và liệu pháp phát huy hiệu quả tối ưu. Nếu có bất kỳ dấu hiệu bất thường nào, hãy thông báo ngay cho bác sĩ hoặc chuyên gia để được tư vấn kịp thời.
Chăm sóc bản thân sau khi thực hiện lọc máu xấu trẻ hoá làn da không chỉ giúp tối ưu hóa kết quả điều trị mà còn góp phần duy trì sức khỏe và vẻ đẹp lâu dài của làn da.
>>> Tham khảo thêm những kiến thức y học hiện đại và kinh nghiệm chăm sóc sức khỏe tại đây.
Phương pháp lọc máu xấu trẻ hoá làn da không chỉ là một giải pháp tiên tiến giúp làm sạch cơ thể, mà còn đóng vai trò quan trọng trong việc trẻ hóa làn da và tái tạo năng lượng. Việc thanh lọc độc tố giúp da căng mịn, tươi trẻ hơn từ bên trong, đồng thời giúp cơ thể khỏe mạnh, sảng khoái mỗi ngày.
Lựa chọn lọc máu xấu trẻ hoá làn da như một liệu pháp ưu việt để duy trì sắc đẹp và năng lượng bền vững!
Xem thêm>>>>>
Lọc máu xấu giảm mỡ máu và những lợi ích bất ngờ
Nhận biết thời điểm vàng lọc máu xấu thanh lọc cơ thể
Bí quyết sống khoẻ mạnh nhờ lọc máu xấu cho phụ nữ từ 40 - 60 tuổi